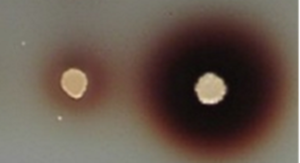

山口大学 工学部 応用化学科
山口大学大学院 創成科学研究科
分子生命機能工学研究室
研究テーマ
耐熱性酵母を用いた環境にやさしい有用物質生産系の開発
耐熱性酵母のKluyveromyces marxianus(読み方はクルイベロマイセス マルシアナス)は50℃でも生育できる耐熱性の酵母です。さらに,エタノールを作る能力も持っています。この2つの能力を上手く生かすと,使用エネルギーが少ない,別の言い方をするとCO2の排出が少ないプロセスでバイオエタノールの生産が可能になります。バイオエタノール自体もCO2削減効果のあるエネルギーですが,それをよりCO2の排出が少ない方法で生産できることになります。

耐熱性酵母Kluyveromyces marxianusの電子顕微鏡像
Kluyveromyces marxianusは酵母の中でも出芽酵母を呼ばれる酵母です。左の電子顕微鏡像で楕円や円形をしているのが,酵母の細胞。それらが2つ繋がっているのは,細胞分裂をしようとしている酵母です。拡大画像では細胞内にミトコンドリアも見られます。
化石資源が不足すると,あるいは化石資源の使用を抑えるには,生物を利用した化学材料の生産にシフトしていくことが求められています。この耐熱性酵母の遺伝子組換え系を構築したので,Kluyveromyces marxianusに様々な遺伝子を導入して,汎用化学品や複雑な構造を持つ生理活性分子(医薬品)などの有用な分子を合成することも目指しています。
さらに,Kluyveromyces marxianusは化学品生産原料に色々な種類の糖を利用できることも,つまり幅広いバイオマス資源を有効活用できること特徴です。これまで利用されてこなかったバイオマスを有効活用して有用物質を生産するための研究を進めています。

タイの高温発酵試験パイロットプラント
耐熱性酵母の高温発酵能を示す動画
タンパク質大量生産法の開発
タンパク質は細胞内の代謝を担う酵素,細胞外の糖などを分解する酵素,生体防御機構の担い手である抗体,細胞機能を制御するホルモンやサイトカインなどいろいろなものがあります。酵素は物質生産や食品加工に利用されていて,サイトカインには医薬品として使用されています。利用するためにはたくさんのタンパク質が必要ですが,例えばヒトの生産するタンパク質を人から大量に取り出すことは難しいので,遺伝子工学的に生産します。ところが,セントラルドグマの原理からすると簡単に生産できるはずの組換えタンパク質がなぜかうまく作れないのが遺伝子工学の大きな課題です。タンパク質の生産を困難にしている原因を明らかにし,それを克服する方法を開発しています。


タンパク質を生産させる酵母の遺伝子を改変して,タンパク質生産量を増強した。左はラッカーゼという酵素,右はアミラーゼ。中央の白い円形が組換え酵母部分,その周りの赤茶色,薄い黄色の範囲が広いほど酵素をたくさん生産している。
他にもいろいろ
簡単に手に入らない遺伝子は,遺伝子を全合成
普段研究室で扱っていない生物,例えばサンゴの遺伝子などはデータベース上の配列をもとに遺伝子を人工的に合成して利用しています。サンゴの色素タンパク質を作ってみるカラフルな酵母が得られました(下の写真)。

抗原-抗体結合の解析
目的の抗原に対して特異的に結合できる抗体をデザインしたい。
原核生物の機能を真核生物に移植
生物の基本分類の原核生物と真核生物。原核生物のタンパク質複合体を真核生物で機能させられるだろうか。
酵母が脂肪を蓄積
耐熱性酵母を調べていると環境依存的に脂肪が蓄積する様子が観察されました。何のために,どういう仕組みで貯めるのかを調べています。
人工配列を使って生物の機能を調べる,生物に新しい機能を与える
タンパク質の配列を見てもその意味は全く分かりません。意味を知るためにどんどん単純化していくと自然には無い人工的な配列になります。そこから,本来の機能を持つものと失うものを探していくと,配列の意味が解ってきます。
耐熱性酵母のKluyveromyces marxianus(読み方はクルイベロマイセス マルシアナス)は50℃でも生育できる耐熱性の酵母です。さらに,エタノールを作る能力も持っています。この2つの能力を上手く生かすと,使用エネルギーが少ない,別の言い方をするとCO2の排出が少ないプロセスでバイオエタノールの生産が可能になります。バイオエタノール自体もCO2削減効果のあるエネルギーですが,それをよりCO2の排出が少ない方法で生産できることになります。

耐熱性酵母Kluyveromyces marxianusの電子顕微鏡像
Kluyveromyces marxianusは酵母の中でも出芽酵母を呼ばれる酵母です。左の電子顕微鏡像で楕円や円形をしているのが,酵母の細胞。それらが2つ繋がっているのは,細胞分裂をしようとしている酵母です。拡大画像では細胞内にミトコンドリアも見られます。
化石資源が不足すると,あるいは化石資源の使用を抑えるには,生物を利用した化学材料の生産にシフトしていくことが求められています。この耐熱性酵母の遺伝子組換え系を構築したので,Kluyveromyces marxianusに様々な遺伝子を導入して,汎用化学品や複雑な構造を持つ生理活性分子(医薬品)などの有用な分子を合成することも目指しています。
さらに,Kluyveromyces marxianusは化学品生産原料に色々な種類の糖を利用できることも,つまり幅広いバイオマス資源を有効活用できること特徴です。これまで利用されてこなかったバイオマスを有効活用して有用物質を生産するための研究を進めています。

タイの高温発酵試験パイロットプラント
耐熱性酵母の高温発酵能を示す動画
タンパク質大量生産法の開発
タンパク質は細胞内の代謝を担う酵素,細胞外の糖などを分解する酵素,生体防御機構の担い手である抗体,細胞機能を制御するホルモンやサイトカインなどいろいろなものがあります。酵素は物質生産や食品加工に利用されていて,サイトカインには医薬品として使用されています。利用するためにはたくさんのタンパク質が必要ですが,例えばヒトの生産するタンパク質を人から大量に取り出すことは難しいので,遺伝子工学的に生産します。ところが,セントラルドグマの原理からすると簡単に生産できるはずの組換えタンパク質がなぜかうまく作れないのが遺伝子工学の大きな課題です。タンパク質の生産を困難にしている原因を明らかにし,それを克服する方法を開発しています。

タンパク質を生産させる酵母の遺伝子を改変して,タンパク質生産量を増強した。左はラッカーゼという酵素,右はアミラーゼ。中央の白い円形が組換え酵母部分,その周りの赤茶色,薄い黄色の範囲が広いほど酵素をたくさん生産している。
他にもいろいろ
簡単に手に入らない遺伝子は,遺伝子を全合成
普段研究室で扱っていない生物,例えばサンゴの遺伝子などはデータベース上の配列をもとに遺伝子を人工的に合成して利用しています。サンゴの色素タンパク質を作ってみるカラフルな酵母が得られました(下の写真)。

抗原-抗体結合の解析
目的の抗原に対して特異的に結合できる抗体をデザインしたい。
原核生物の機能を真核生物に移植
生物の基本分類の原核生物と真核生物。原核生物のタンパク質複合体を真核生物で機能させられるだろうか。
酵母が脂肪を蓄積
耐熱性酵母を調べていると環境依存的に脂肪が蓄積する様子が観察されました。何のために,どういう仕組みで貯めるのかを調べています。
人工配列を使って生物の機能を調べる,生物に新しい機能を与える
タンパク質の配列を見てもその意味は全く分かりません。意味を知るためにどんどん単純化していくと自然には無い人工的な配列になります。そこから,本来の機能を持つものと失うものを探していくと,配列の意味が解ってきます。